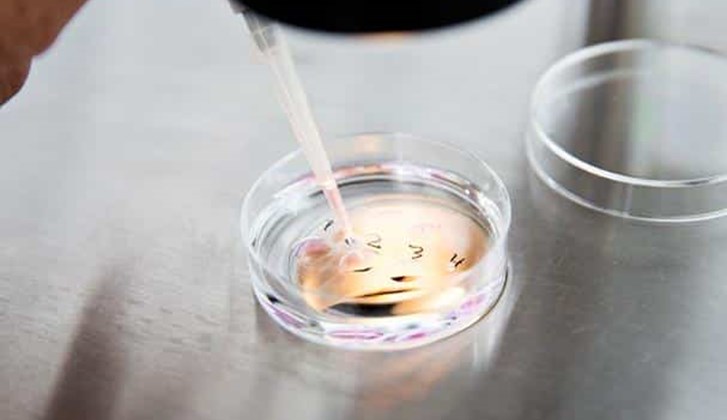
Vilken är skillnaden mellan IVF-behandling och insemination?

Mer fakta
Fertilitetsråd och nyheter | Vitanova
09.07.25
Kvinnor vill ha en skonsammare behandling med färre fysiska och emotionella påfrestningar ”Jag vill inte känna att min kropp är utom kontroll. Jag vet inte hur jag skulle klara av humörsvängningar eller injektioner varje dag!" Vid konventionell IVF ges läkemedel i form av dagliga injektioner (e...
28.07.23
Varje år behöver cirka 600 danska kvinnor donerade ägg. Vissa kvinnor kan ha kommit i klimakteriet tidigt eller fått äggstockarna bortopererade på grund av sjukdom. Andra kvinnor bär på allvarliga genetiska avvikelser som de inte vill överföra till sina barn. Vid äggdonation donerar en kvinna nå...
19.05.21
Vi har länge varit banbrytande och utfört naturlig och mild IVF som ett säkrare alternativ till konventionell IVF-behandling. Vårt tillvägagångssätt ger resultat som är lika med eller bättre än det nationella genomsnittet för IVF, samtidigt som det är skonsammare mot kvinnans kropp och innebär b...
19.05.21
Denna behandling är skonsam både för dig som kvinna och ditt barn. Vi arbetar nämligen med din kropp, inte emot den. Om du har problem med fertilitet – och ett av sju par runt om i landet befinner sig i den här situationen – är det troligt att du går och bär på följande känslor: Frustration - f...
19.05.21
Hur skiljer sig mild och naturlig IVF från konventionell IVF? Mild och naturlig IVF skiljer sig från konventionell IVF i tillvägagångssättet. Medan man vid mild och naturlig IVF har fokus på kvaliteten på de utplockade äggen och arbetar inom kvinnans naturliga menstruationscykel, använder man vi...
18.05.21
Vi är medvetna om att det finns många termer, akronymer och förkortningar att hålla reda på och förstå när det gäller fertilitet. Vi har därför skapat en egen fertilitetsordlista så att du vet allt när det väl är dags för din fertilitetsbehandling: Förstå hormone AMH: står för anti-Müllerskt hor...
18.05.21
Vad är naturlig IVF? Naturlig IVF är en IVF-behandling som innebär användning av färre läkemedel än vid konventionell IVF och som utförs inom kvinnans naturliga cykel. Vid konventionell IVF används läkemedel i syfte att avbryta menstruationscykeln (”nedreglering”) och starta om den igen varpå st...
18.05.21
1. Infertilitet är inte ovanligt Tyvärr är infertilitet inte så ovanligt idag som det har varit. Statistiskt sett påverkar infertilitet ett av sex par. Infertiliteten beror på kvinnan i 40 % av fallen, mannen i 40 % av fallen och båda parter i 20 % av fallen. Det är i många fall omöjligt att säg...
18.05.21
Assisterad befruktning eller ART (assisterad reproduktionsteknik) kallades förr konstgjord befruktning. Vi gillar tanken på att vi hjälper till med befruktning, så assisterad befruktning är den term vi normalt använder. Mer information om metoderna som används vid assisterad befruktning finns hä...
27.01.21
Den dåliga spermakvaliteten kan innebära att uppemot 15 procent kan ha svårt att göra sin partner gravid utan fertilitetsbehandling och att 25 procent får räkna med att det dröjer längre att bli gravid än väntat.Det finns många råd om hur män kan förbättra sin spermakvalitet. De ska undvika trån...
27.01.21
Kvinnor som har passerat 35 års ålder och ännu inte har fått barn känner ofta att de är under tidspress om de ska hinna få barn, och de är mycket bekymrade över sin fertilitet. Men det är viktigt att förstå att fertiliteten inte sjunker tvärt utan att det sker som en glidande övergång.Det finns...
27.01.21
Det kan vara stressande när graviditeten uteblir, men kan stress och bekymmer påverka dina chanser att bli gravid?Det har gjorts många undersökningar för att utröna om stress kan påverka fertiliteten, och det är begränsat vad undersökningarna har visat.Men man anser att en mycket hög stressnivå...
27.01.21
Befruktningen äger rum ungefär två veckor före förväntad menstruation och därför vet inte många att de är gravida innan de är minst i 2–3 veckan. Fostret är som mest känsligt för skadlig påverkan tidigt i graviditeten, i vecka 3–8, när organen bildas.Därför är det en god idé att bete sig som om...
27.01.21
När du är gravid är det särskilt viktigt att du äter hälsosamt och varierat. Om det saknas något i din kost kan det påverka barnets utveckling. Därför är en graviditet en bra anledning till att se över dina matvanor och fundera på om det är några livsmedel som saknas i din kost.Det är inte nödvä...
27.01.21
IVF / PROVRÖRSBEHANDLING Provrörsbehandling förkortas ofta IVF, som står för in vitro fertilisering och innebär att befruktningen äger rum utanför kvinnans kropp i ett provrör.Vid IVF-behandlingen plockas ägg ut från äggstockarna för att bli befruktade med sperman i ett laboratorium. Äggen plock...
27.01.21
Det finns olika donationsformer: anonym, öppen eller känd donator. I den här artikeln beskriver vi skillnaden mellan de olika donationsformerna. Vid anonym ägg- eller spermadonation kan kvinnan/paret bara få information om donatorns hudfärg, hårfärg, ögonfärg, längd, vikt och etnicitet (grundläg...
27.01.21
Könssjukdomar bör förebyggas genom att inte ha oskyddat sex, och könssjukdomar bör behandlas. Infektioner efter könssjukdomar kan nämligen leda till ofrivillig barnlöshet hos både män och kvinnor. Övervikt och undervikt kan minska chansen att bli gravid, då vikten har betydelse för hormonbalans...
27.01.21
Kvinnan har störst chans att bli gravid samma dag som ägglossningen sker eller dagen innan. Ett ägglossningstest är ett enkelt och säkert sätt att förutse ägglossningen och därmed den fertila period som varar i 5–7 dagar. Ägglossningstestet mäter koncentrationen av ägglossningshormonet LH (lutei...
27.01.21
Många män tycker att det är obekvämt och gränsöverskridande att åstadkomma ett spermaprov på kommando på en klinik. Det kan för många män därför vara en god nyhet att det nu är möjligt att göra ett självtest hemma. Danska specialister har utvecklat ett självtest som kan ge en fingervisning om sp...
27.01.21
Endometrios är en kronisk sjukdom som kan finnas hos 4–7 procent av alla kvinnor. Celler som liknar livmoderslemhinnan (endometriet) finns utanför livmodern, huvudsakligen på äggstockar, äggledare, utsidan av livmodern och i bukhålan. Dessa celler uppför sig som cellerna i livmodern och blöder vi...
27.01.21
Om du är gravid eller önskar bli gravid är det viktigt med en hälsosam livsstil för både dig och ditt barn. På Vitanova har vi samlat en del råd för hur du skapar goda vanor i ditt liv, både före, under och efter din graviditet. MOTION God kondition, starka muskler och leder och ett starkt skel...
27.01.21
Det kan finnas många orsaker till att en kvinna inte blir gravid under de första åren man försöker. I denna artikel beskriver vi de vanligaste orsakerna till infertilitet hos kvinnor. De vanligaste orsakerna till barnlöshet hos kvinnor är: Blockerade äggledare Oregelbunden eller utebliven ägg...
26.11.20
Vid önskemål kan du få akupunktur i samband med din behandling. Akupunkturen verkar dels avslappnande men studier har även visat att graviditetschanserna ökar.Akupunkturen ges när du ligger på behandlingsbritsen så du behöver oftast inte flytta dig innan behandling. Akupunkturen utförs innan beh...
26.11.20
För att förstå vad infertilitet verkligen betyder tar vi utgångspunkt i fertilitet, alltså förmågan till att får barn. Ett flickfoster föds med ca 400,000 omogna ägg (oocyter). Oocyterna återfinns i äggstockarna och det första ägget mognar när flickan är i puberteten vid ca 13 års ålder. Kvinnan...
26.11.20
Vid samtalet inför insemination eller IVF kommer vi bland annat prata om livsstil och fertilitet. Fertilitet eller fruktbarhet kan mätas i den tid som går från det att man beslutar sig för att bli gravid fram till det lyckas. Detta tidsrum varierar från person till person men ökar generellt med...